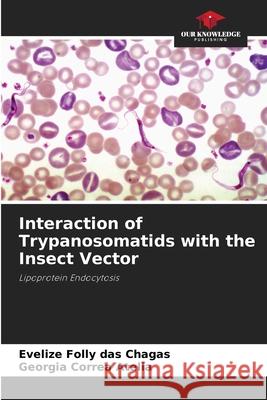
Interaction of Trypanosomatids with the Insect Vector Folly das Chagas, Evelize, Correa Atella, Georgia 9786202370394 Our Knowledge Publishing - książka

Interaction of Trypanosomatids with the Insect Vector » książka
topmenu
Interaction of Trypanosomatids with the Insect Vector
ISBN-13: 9786202370394 / Angielski / Miękka / 2025 / 76 str.
In the Americas, two species of trypanosomes have a high incidence and medical importance: Trypanosoma cruzi and Trypanosoma rangeli. These two parasites use invertebrate hosts, members of the Reduviidae family, especially Rhodnius prolixus. During its life cycle, T. rangeli crosses the intestinal epithelium and invades the insect's hemolymph, while T. cruzi remains in the lumen of the vector's intestine. In the present study, we demonstrate for the first time the uptake of lipophorin (Lp), which is the main lipid transport particle in the insect's hemolymph, by these trypanosomes.